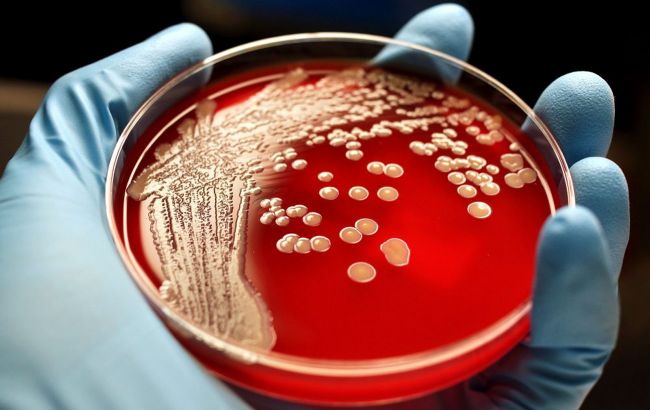

Под Одессой обнаружена сибирская язва: какие симптомы у больного
Под Одессой мужчина заболел сибирской язвой (фото: azattyq-ruhy.kz)
Под Одессой мужчина заболел сибирской язвой (фото: azattyq-ruhy.kz)
У мужчины в Одесской области обнаружена сибирская язва
В Одесской области у мужчины диагностировали сибирскую язву. У местного жителя подскочила температура тела и на голени возник фурункул, который потом трансформировался в язву. Об этом написали на странице Центра общественного здоровья Украины в Facebook.
Отмечается, что первые симптомы появились у мужчины 3 августа, но в больницу он обратился только 7 августа. Известно, что заболевший занимается покупкой животных для дальнейшей перепродажи.
11 августа референс-лаборатория Центра общественного здоровья Украины методом ПЦР выделила ДНК сибирской язвы. Специалисты областного лабораторного центра и Держпродслужбы принимают необходимые меры по недопущению распространения заболевания.
Организовано медицинское наблюдение за контактными, проведения полного комплекса противоэпидемических и профилактических мероприятий в очаге.
Для справки
Сибирская язва не передается от человека к человеку. Заражение человека сибирской язвой возникает вследствие проникновения возбудителя через поврежденную кожу или слизистые оболочки при уходе за больными животными, при обработке туш, снятии кожи и захоронение трупов погибших животных, при контакте с различными видами сырья, полученного от больных животных, при употреблении в пищу мягкие мяса больных животных, а через укусы кровососущих насекомых путями. Не исключается заражение через почву или предметы, загрязненные возбудителем.
Как мы ранее писали, последняя крупная вспышка сибирской язвы в Украине была зафиксирована также в Одесской области; тогда на карантин закрыли два села и госпитализировали нескольких человек.
